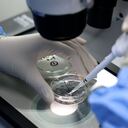
Un trabajador de laboratorio trabajando en una empresa de biotecnología en el condado de Yangxin, en la provincia de Shandong, en el este de China. Foto de CHU BAORUI / Feature China/Future Publishing vía Getty Images

El dolor abdominal es una de las dolencias más comunes, pues se podría afirmar que todas las personas han sufrido de este tipo de malestar en algún momento de su vida. Aunque no siempre es necesario acudir a un especialista o empezar un fuerte tratamiento, es bueno conocer sus causas y cuando hay que prender las alarmas frente a este tipo de dolor.
La ubicación del dolor, el comportamiento de este dolor y, sobre todo, la duración del mismo, pueden ser dos indicios importantes que indican en un momento dado si se está hablando de una molestia o si hay que acudir a un centro médico.

Tipos de dolor y características
No todos los dolores abdominales son iguales y por eso, lo primero que hay que determinar es si se está hablando de un dolor agudo, cónico o progresivo.
El dolor abdominal agudo desaparece después de una cuantas horas o en el peor de los caos, algunos días. Cuando se habla de dolor crónico tiende a aparecer y a desaparecer y puede persistir durante meses, mientras que el progresivo tiende a ir empeorando con el tiempo.
Dolor abdominal agudo
Las causas del dolor abdominal agudo pueden oscilar entre afecciones sin mayor importancia que desaparecen sin tratamiento y emergencias médicas graves, entre las que se incluyen:
- Aneurisma aórtico abdominal
- Apendicitis
- Colangitis, que es la inflamación del conducto biliar.
- Colecistitis
- Cistitis (irritación de la vejiga)
- Cetoacidosis diabética (en la que el cuerpo tiene niveles elevados de ácidos en la sangre llamados cetonas)
- Diverticulitis
- Duodenitis, es decir, una inflamación de la parte superior del intestino delgado.
- Embarazo ectópico (en el que el óvulo fecundado se implanta y crece fuera del útero, como en una trompa de Falopio)
- Impactación fecal, que consiste en heces duras que no pueden expulsarse.
- Ataque cardíaco.

- Una lesión.
- Oclusión intestinal.
- Invaginación (en niños).
- Infección renal (también llamado pielonefritis).
- Cálculos renales (objetos duros que se forman debido a las sustancias químicas en la orina).
- Un absceso hepático es una acumulación de pus en el hígado.
- Isquemia mesentérica.
- Linfadenitis mesentérica.
- La trombosis mesentérica se produce cuando hay un coágulo sanguíneo en una vena que transporta sangre desde los intestinos.
- Pancreatitis.
- Pericarditis.
- Peritonitis.
- Pleuresía.
- Neumonía Una infección en uno o ambos pulmones.
- Infarto pulmonar, que es la pérdida de flujo sanguíneo a los pulmones.
- Rotura de bazo
- Salpingitis, que es la inflamación de las trompas de Falopio.
- Mesenteritis esclerosante
- Infección de herpes zóster
- Infección del bazo
- El absceso esplénico es una acumulación de pus en el bazo.
- Desgarro del colon.
- Infección de las vías urinarias.
- Gastroenteritis vírica.

Dolor abdominal crónico (intermitente o episódico)
De acuerdo a lo que se informa en el portal mayoclinic.org, algunas de las afecciones que pueden causar dolor abdominal crónico son:
- Angina de pecho
- Celiaquía
- Endometriosis
- Dispepsia funcional
- Cálculos biliares
- Gastritis (inflamación del revestimiento del estómago)

- Enfermedad por reflujo gastroesofágico
- Hernia de hiato
- Hernia inguinal.
- Síndrome de intestino irritable
- Dolor intermenstrual
- Quistes de ovario
- Enfermedad inflamatoria pélvica
- Úlcera péptica
- Anemia de células falciformes
- Esguince o distensión de los músculos del abdomen.
- Colitis ulcerosa.
Dolor abdominal progresivo
El mismo portal en mención hace referencia a que algunas de las causas del dolor abdominal progresivo, pueden ser:
- Cáncer
- Enfermedad de Crohn
- Bazo dilatado
- Cáncer de vesícula
- Hepatitis

- Cáncer de riñón
- Intoxicación por plomo
- Cáncer de hígado
- Linfoma no hodgkiniano
- Cáncer de páncreas
- Cáncer de estómago
- Un absceso de las trompas o los ovarios es una acumulación de pus que afecta una trompa de Falopio y un ovario.
- Uremia
Lo importante es estar atentos cuando aparece este tipo de dolores, pues puede ser el inicio de una delicada enfermedad que deba tratar con su médico de confianza.
